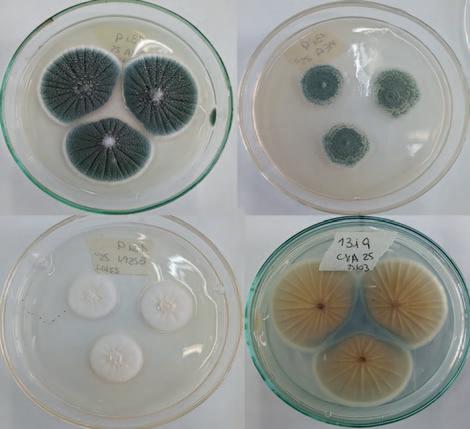

22 minute read
Evaluación del riesgo de la presencia de hongos toxicogénicos en la industria chacinera
from La Industria Cárnica Latinoamericana Nº 227
by Publitec - Editora especializada en ciencia y tecnología de alimentos
Ducret F.G.1, Latorre Rapela M.G.2, Comelli R.3, Benzzo M.T.1
Laboratorio de Ingeniería Ambiental - Facultad de Ingeniería y Ciencias Hídricas – UNL. Santa Fe, Argentina.
Advertisement
Cátedra de Microbiología General - Facultad de Bioquímica y Ciencias Biológicas – UNL. Santa Fe, Argentina.
Departamento de Medio Ambiente. Facultad de Ingeniería y Ciencias Hídricas - UNL. Santa Fe, Argentina. Consejo Nacional de Investigaciones Científicas y Técnicas (CONICET), mtbenzzo@fich.unl.edu.ar
Resumen
Durante la elaboración de los productos cárnicos crudo-curados fermentados, las etapas de maduración y secado constituyen puntos críticos en lo que refiere a la calidad higiénico-sanitaria de los mismos. La colonización superficial de estos productos por diferentes cepas fúngicas les otorga características organolépticas específicas, protegiéndolos además de la luz y el oxígeno e inhibiendo el desarrollo de bacterias indeseables. No obstante, el fuerte componente artesanal y/o las deficiencias inherentes al proceso productivo y la infraestructura, permi- ten la contaminación con especies potencialmente toxigénicas presentes en el ambiente. Este trabajo contempló el relevamiento de la microflora fúngica estacional (invierno-verano) presente en el sector de los secaderos de dos plantas de chacinados, ubicadas en la ciudad de Santa Fe. Una de éstas realizaba elaboración artesanal y la otra automatizada. Un total de 46 aislamientos de hongos filamentosos provenientes del ambiente, superficies de embutidos e insumos (tripa/CIF), fueron caracterizados macroscópicamente y microscópicamente hasta la identificación de género. Todos los aislamientos pertenecientes al género Penicillium y Aspergillus (15/46) se caracterizaron a nivel de Serie o Especie siguiendo las claves taxonómicas de Pitt & Hocking. La capacidad toxigénica de los hongos caracterizados morfológicamente, reportados en la bibliografía como tales (22/46), se evaluó a través del bioensayo de Artemia salina. Para ello, se emplearon diluciones (1/10, 1/50, 1/100) de los sobrenadantes (SN) provenientes de los cultivos de los hongos tras siete días de crecimiento, en las condiciones específicas del bioensayo, por triplicado. Un total de diez aislamientos presentaron toxicidad leve (DT) y dos fueron tóxicos (T), mientras que diez resultaron no tóxicos (NT). El test no paramétrico de Kruskal y Wallis determinó la existencia de diferencias significativas (p<0,05) entre el Control y las diluciones de los SN, pero no entre estas últimas. Teniendo en cuenta los tiempos de residencia de los chacinados en los secaderos (cuatro a siete días según el proceso operativo de las empresas involucradas), la naturaleza de la matriz alimentaria (relación proteína/grasa) y de las sustancias toxicogénicas (migración al interior del embutido), se consideró, para la evaluación del riesgo, la menor dilución de los SN fúngicos. Estos resultados identificaron a priori el riesgo químico asociado a la presencia de hongos ambientales toxicogénicos y micotoxicogénicos que comprometen la inocuidad alimentaria.
Palabras clave: embutidos crudo-curados, toxicidad fúngica, secadero, inocuidad alimentaria.
Introducci N
La producción de chacinados y embutidos crudocurados reviste gran importancia socio-económica en la Argentina debido al elevado consumo per cápita, destacándose numerosas fábricas radicadas en Buenos Aires, Santa Fe y Córdoba, con importantes diferencias en sus sistemas productivos y en la infraestructura de las instalaciones, lo cual impacta en la seguridad alimentaria. Muchos de estos productos se vinculan a la cultura asociada a su elaboración, origen geográfico y condiciones locales de producción, configurándose como un sistema de calidad diferenciada y agregado de valor, tales como los “Alimentos con Sello Argentino”, “Sistema de Indicación Geográfica” y “Denominación de Origen”.
Durante el proceso productivo, específicamente durante las etapas de maduración y secado, el crecimiento de hongos y levaduras sobre la tripa juega un rol importante en el desarrollo de las características organolépticas del producto final, protegiéndolo de la luz y el oxígeno e inhibiendo el desarrollo de bacterias indeseables3. Por otra parte, los hongos asociados al emplume de embutidos crudo-curados involucran especies de Penicillium, tales como P. nalgiovense, P. olsonii, P. chrysogenum, P. verrucosum, P. spathulatum, P.solitum, P. oxalicum, P. commune, P. camemberti, P. expansum, P. miczynskii y P. simplicissimum17;18; 27; 9; 1. Se asocian, además, especies contaminantes como P. aurantiogriseum19 y de
HAY CONOCIMIENTO, TECNOLOGÍA y TRATAMIENTOS ESPECIALES
GranoGel Cárnic a Tecnología en carrageninas y gomas que aportan viscosidad y textura evitando sinéresis
CONOCÉ
GranoProt Cárnic a Proteínas miofibrilares y colágeno con capacidad emulsionante y de retención de agua
GranoFos
Fosfatos de alta solubilidad que regulan el pH favoreciendo la solubilización de proteínas para productos de inyección, emulsión, embutidos y tratamiento de sangre

Soluciones T ecnológicas Innovadoras
> Sustitutos de grasas
> Sustitutos de sal
Otros Ingredientes
> Resaltadores de Sabor
> Antioxidantes
> Conservantes tradicionales y naturales
> Núcleos funcionales para análogos cárnicos DISTRIBUIDOR
> Fibras funcionales que aportan estructura los géneros Aspergillus, Scopulariopsis, Rhizopus, Eurotium, Cladosporium y Mucor5 los cuales, en función de la actividad acuosa (aw), alteran la calidad sensorial del producto.
Existen numerosos trabajos que reportan la producción de compuestos toxicogénicos y micotoxigénicos en productos cárnicos crudo-curados secos y semisecos26; 22; 18; 15; 3; 4; 12; 7; 24. Peromingo et al. (2019) demostraron la difusión de metabolitos secundarios, ocratoxina A (OTA) y ácido ciclopiazónico (CPA), al inocular salchichas fermentadas y jamón crudo con P. nordicum, P. verrucosum y P. griseofulvum, simulando el proceso de maduración industrial. Los metabolitos secundarios difundían desde la superficie, contaminando los productos hasta los 3 cm de profundidad, siendo mayor en las salchichas fermentadas respecto del jamón crudo.
Aunque los niveles detectados de compuestos tóxicos de origen fúngico han sido pequeños y limitados a no más de unos pocos milímetros bajo la superficie del embutido o chacinado, el crecimiento de mohos no deseables debería evitarse, no sólo por el riesgo de formación de micotoxinas y antibióticos, sino también por los defectos que provocan sobre la calidad sensorial del producto. Resulta común, entre los fabricantes de chacinados, cepillar o lavar el producto previo a su expedición, espolvoreándolos con fécula o envasándolos al vacío. No obstante, la remoción del micelio fúngico no asegura un alimento inocuo desde el punto de vista toxicológico, ya que podría haber difusión previa de metabolitos secundarios al interior del producto. Así, la práctica de remover la superficie enmohecida de estos productos cárnicos no elimina el riesgo16; 20. Por otra parte, el uso de starters comerciales (CIF) compuestos por hongos no micotoxigénicos y no productores de antibióticos, adaptados al proceso de maduración, permite controlar poblaciones microbianas indeseables a la vez que estandariza la producción13; 23; 28. De esta manera, la clave radica en dirigir la ecología microbiana del producto durante las etapas de maduración y secado para asegurar la inocuidad y calidad sensorial2. No obstante, resulta necesario tener un estricto control del ambiente de producción y de mantenimiento preventivo de las instalaciones6.
No existen criterios establecidos en la legislación actual respecto de las especies fúngicas “permitidas” a nivel de la superficie de embutidos crudocurados secos, aunque se ha demostrado que muchos de los incluidos en los CIF son potencialmente toxicogénicos. Hasta el momento, Italia es el único país que ha adoptado lineamientos más estrictos para la presencia de OTA en productos cárnicos (OTA < 1 µg/kg), teniendo en cuenta el elevado consumo per cápita y el posible impacto en la Salud Pública de no establecerse esta medida. Por otra parte, si bien el reglamento europeo (CE Nº 1881/2006) establece límites máximos de ciertas micotoxinas en diferentes categorías de alimentos, no incluye a los productos cárnicos fermentados. Nuestra legislación alimentaria (CAA) tampoco establece (o recomienda) criterios en referencia a las especies fúngicas permitidas en la superficie de estos productos cárnicos. Teniendo en cuenta que el consumo per cápita de estos productos ha aumentado notablemente en los últimos años y que cada vez son más las reacciones alérgicas ante el consumo de ciertos alimentos, resulta de interés evaluar el riesgo de la presencia de hongos toxicogénicos en el ámbito industrial.
El presente trabajo de investigación planteó caracterizar los hongos filamentosos presentes en el ambiente de los secaderos de dos fábricas de chacinados de la ciudad de Santa Fe, determinando su capacidad toxicogénica, a fin de evaluar el riesgo químico presente en embutidos crudo-curados secos y semisecos.
Materiales Y M Todos
Aislamiento de hongos en el ambiente productivo Se realizó un muestreo estacional (invierno-verano) en el sector de los secaderos de dos fábricas de chacinados de Santa Fe, una de elaboración artesanal (sin CIF y tripa natural, empresa B) y otra automatizada (con CIF y tripa artificial, empresa A). Los productos se seleccionaron en función del nivel de producción y la contaminación observada al momento del muestreo. Para ello se realizó un hisopado14 de la superficie de los productos en proceso, seleccionando aquellos que presentaban manchas negras, amarillas, naranjas y verdes. Las muestras se conservaron y trasladaron en tubos cerrados con solución fisiológica estéril bajo condiciones de refrigeración. Las muestras se sembraron en estría, utilizando Agar Extracto de Malta (AEM) a 25°C, 7-10 días en condiciones de aerobiosis. Las colonias macroscópicamente diferentes se repicaron al mismo medio por siembra puntual hasta la obtención de cultivos axénicos, asignando a cada aislamiento un código que permitió correlacionar la fecha de muestreo, tipo y lote del producto y la empresa (trazabilidad del muestreo).
El aislamiento de hongos del ambiente de los secaderos se realizó por exposición de placas de Petri con AEM durante 15 minutos, altura estándar (1,0-1,5 m del suelo). Culminado el tiempo de exposición, las placas se cerraron y trasladaron al laboratorio incubándolas a 25°C, 7-10 días en aerobiosis. Cada aislamiento (cultivo axénico) se caracterizó macroscópicamente (observación de la colonia gigante) y microscópicamente mediante la técnica de cinta engomada, fragmento de colonia y/o microcultivo. Los aislamientos se sembraron en tubos con AEM (en rampa), conservándolos a 4°C como stock de trabajo. Además se conservaron por triplicado en viales a -80°C, en caldo YPG suplementado con 20% de glicerol, como stock permanente.
Caracterizaci N E Identificaci N Morfol Gica
Del total de los aislamientos realizados, se seleccionaron aquellos pertenecientes a los géneros reportados como toxicogénicos y micotoxigénicos en la bibliografía: Penicillium, Aspergillus, Alternaria, Fusarium, Trichoderma. Para la caracterización e identificación morfológica de los aislamientos pertenecientes a los géneros Penicillium y Aspergillus, se realizaron las técnicas clásicas propuestas por Pitt and Hocking (1999). Se utilizaron los medios Agar Czapek con Extracto de Levadura (CYA), Agar Nitrato con 25% de Glicerol (G25N) y Agar Extracto de Malta (AEM). Las placas de Petri con medio MEA y G25N (20 mL/placa) se incubaron a 25°C en aerobiosis, mientras que las que contenían CYA, se incubaron a 5°, 25° y 37°C. En los casos que se identificó un aislamiento de Penicillium subgénero penicillium se utilizó CSN (CREA modificado), medio que aplica a la identificación de hongos xerófilos a 25°C (21).
Cada aislamiento se sembró de manera puntual en tres puntos equidistantes del borde y centro de la placa de Petri. La lectura se efectuó a los siete días de la siembra, previa calibración del ocular micrométrico. Se determinó así el diámetro de las colonias, apariencia, textura, formación de estrías y surcos superficiales, producción de exudados y pigmentos solubles que difunden al medio de cultivo, coloración del micelio, de los conidios o esporas, así como del reverso de la colonia. Todos los que presentaron idéntica descripción macroscópica se agruparon para luego ser identificados empleando las claves de referencia. Las colonias obtenidas a 5°C y 37°C se observaron mediante lupa estereoscópica a fin de comprobar si el crecimiento o la germinación estaban presentes. Las observaciones microscópicas se realizaron a partir de las colonias crecidas en los medios CYA y MEA, mediante las técnicas de fragmento de colonia y/o cinta engomada con azul de lactofenol para evidenciar la textura superficial de las hifas, la presencia de cuerpos de fructificación, su diámetro, forma y arquitectura externa de los conidios y esporas. En el caso de los aislamientos de Penicillium, se registró el número de ramificaciones de la estructura reproductiva, longitud y textura superficial de los conidióforos, número y longitud de las métulas, fiálides y conidios. En los aislamientos pertenecientes al género Aspergillus, se evaluó la textura superficial del estipe; longitud de las hifas; número y longitud de las métulas, fiálides y diámetro de los conidios; color y diámetro de cleistotecios; textura, forma y diámetro de las cabezas conidiales; textura y forma de las ascosporas.
Evaluaci N De La Toxicidad
La capacidad toxicogénica se determinó a través del bioensayo con larvas de Artemia salina (11; 10; 8). Los huevos de A. salina se reactivaron (40 mg en 100 mL) en una solución de sal marina (2,4% m/v) estéril, incubando a 25°C durante 24 horas, con fotoperiodo natural (11 horas luz/13 horas oscuridad) y aireación reducida (aproximadamente una burbuja/minuto).
Para la obtención de los sobrenadantes (SN) de hongos, se procedió a la inoculación de 104 conidios/mL (estandarizados por cámara de NB) partiendo del cultivo stock, en caldo Extracto de Levadura Sacarosa (YES), un potente inductor de la producción de micotoxinas. Todos los cultivos se incubaron a 25°C, durante siete días con agitación orbital. Se tomaron alícuotas y se centrifugaron (10000 rpm, 10 min.) para eliminar el micelio y se filtraron (0,22 µ m) en condiciones de esterilidad. Posteriormente, se realizaron diluciones con agua estéril (1/10, 1/50 y 1/100) para su posterior evaluación frente a las larvas eclosionadas. El ensayo se realizó en placas de Petri de 5 cm de diámetro con 10 mL/placa de solución de sal marina (2,4% m/v), a la cual se adicionaron 10 larvas vivas y 0,5 mL de la dilución de cada SN fúngico. Las larvas eclosionadas se recolectaron mediante iluminación directa, aprovechando su fototropismo positivo. Cada enfrentamiento (larva-dilución SN fúngico) se realizó por triplicado. El Control consistió en 10 mL de solución salina + 10 larvas vivas, sin SN fúngico. Luego de la incubación (24 horas-25°C) se determinó la mortalidad de las mismas por observación con lupa estereoscópica. El porcentaje (%) de mortalidad se calculó según: tieron diferencias significativas (p < 0,05) entre las tres diluciones de cada uno de los SN fúngicos ensayados respecto del Control, considerando que los datos no presentaron una distribución normal, se utilizó el test no paramétrico de Kruskal y Wallis.
Resultados
Se caracterizaron un total de 46 aislamientos fúngicos procedentes del ambiente de los secaderos, de la superficie de embutidos crudo-curados y de los insumos (tripas), confirmándose estructuras típicas del micelio aéreo en correspondencia con los géneros Penicillium, Aspergillus, Trichoderma, Alternaria, Cladosporium y Fusarium (Gráfico 1).
Gráfico 1 - Resultados del muestreo. Total de hongos filamentosos aislados e identificados a nivel de género en secaderos de plantas de chacinados (empresas AyB).
(nº larvas vivas tratadas x 100) % Mortalidad=100 -
(nº larvas vivas del control)
La toxicidad de las especies se consideró de acuerdo al siguiente criterio: 0-9% de mortalidad: no tóxica (NT), 10-49%: débilmente tóxica (DT), 50-89%: tóxica (T) y 90-100%: muy tóxica (MT).
An Lisis De Datos

Se realizó un análisis estadístico del tipo descriptivo de los resultados del bioensayo, a fin de identificar aquellos aislamientos fúngicos que resultaron toxicogénicos. Adicionalmente, para determinar si exis-
Los aislamientos pertenecientes a Penicillium y Aspergillus (N=15) fueron identificados a nivel de Serie (algunos hasta especie) mediante las claves de Pitt and Hocking. Cinco aislamientos se identificaron como P. nalgiovense, uno como P. camemberti, otro como P. aurantiogriseum, tres correspondieron a la Serie citrina, otros tres a la Serie expansa, uno a la Serie glabra y el último se identificó como Aspergillus chevalieri (Figura 1 a 7)
1 - P. nalgiovense, aislamiento 12H8 proveniente de empresa A. a) Reverso MEA a 25°C, b) Reverso CYA 25°C c) Anverso CSN d) Anverso CYA a 25ºC.
2 - A. chevallieri, aislamiento 12I4 proveniente de empresa A. a) Anverso G25N a 25°C, b) Reverso G25N 25°C c) y d) Microscopia de cleistotecios rodeados de hifas y presencia de ascosporas.





3 - P. aurantiogriseum aislamiento 12H6 proveniente de Empresa A. a) Anverso CYA 25°C; b) Anverso MEA 25°C; c) Anverso G25N 25°C d) Reverso CSN 25° nalgiovense (con origen en la planta A) y otra perteneciente al género Alternaria (de la planta B) resultaron tóxicas (T). Por otro lado, diez aislamientos resultaron débilmente tóxicos (DT) siendo identificados como Alternaria sp., Fusarium sp., P. aurantiogriseum sp., Penicillium de la Serie glabra y de la Serie Citrina, Trichoderma sp. y A. chevallieri sp., todos pertenecientes a la planta A, y otras especies de Fusarium sp., Trichoderma sp. y Alternaria sp. de la planta B (Gráfico 2). El test no paramétrico de Kruskal y Wallis determinó la existencia de diferencias significativas (p<0,05) entre el Control y las distintas diluciones de cada SN de los aislamientos fúngicos estudiados, pero no entre estas últimas. Teniendo en cuenta los tiempos de residencia de los chacinados en los secaderos (4-7 días según POE de cada empresa), la naturaleza de la matriz alimentaria (relación proteína/grasa), la velocidad de secado y las sustancias toxicogénicas (migración desde la superficie al interior del embutido; calibre de la pieza y tipo de picado) se consideró, para su análisis, la menor dilución de los SN fúngicos ensayados (Gráfico 2).
Figura 4 - Serie Citrina, 12I6 proveniente de empresa A. a) Anverso CYA 25°C; b) Anverso MEA 25°C; c) Anverso G25N 25°C; d) Microscopía 40X pincel biverticilado subgénero Furcatum.ras.
El análisis descriptivo de los resultados obtenidos en el bioensayo evidenció que del total de los aislamientos fúngicos (N=22), diez presentaron una toxicidad leve (DT), dos fueron tóxicos (T) y los restantes diez resultaron no tóxicos (NT). De esta manera, para las diluciones 1/10 de cada SN fúngico, dos especies de un total de 22 identificadas como P.

Gráfico 2 - Porcentaje de mortalidad de los aislamientos fúngicos frente a Artemia salina.
permitiera realizar un control automatizado de los factores extrínsecos (temperatura y HRA). Disponían de salas donde se realizaban conjuntamente el estufado y el secado, con temperaturas variables, que oscilaban entre 35º y 40ºC, mediante la colocación de cenizas encendidas por debajo de los productos suspendidos en gancheras. Éstas eran apagadas a medida que se alcanzaba el secado deseado, evaluado por personal calificado asignado a este sector.
Discusi N
Con respecto a la infraestructura y las variables del proceso productivo, la empresa A disponía de secaderos automatizados que permitían fijar los factores extrínsecos que condicionan la etapa de secado. La aireación se realizaba de forma automatizada (por seteo), fijando las condiciones de temperatura y HRA (21-22°C y 70-75 %, respectivamente, observadas al momento del muestreo. La instalación contaba, además, con forzadores que permitían bajar la humedad interna cuando la HRA externa era cercana a 100%. La aplicación del CIF se realizaba (tras el arranque del secadero cargado con el producto) por aspersión, previa preparación del polvo comercial con agua (según instrucciones del fabricante). Por otra parte, la política de calidad del establecimiento no contemplaba un Plan de Monitoreo Ambiental para ninguna de las etapas del proceso. Asimismo, el tiempo de secado se limitaba tan sólo a cuatro o cinco días, priorizando de esta manera la producción frente a la calidad higiénico-sanitaria del producto.
La empresa B se caracterizaba por una elaboración netamente artesanal, sin infraestructura que le
Los resultados de los aislamientos fúngicos del presente trabajo son coincidentes con estudios realizados en otras regiones de nuestro país29. Asimismo, en otros países de América del Sur, se demostró que el género predominante en la microflora superficial de embutidos fue Penicillium30;5;9;18;22. La presencia de ciertas especies de Penicillium en el ambiente productivo representa un problema de índole sanitario, pues son capaces de producir micotoxinas, entre las que se encuentran ocratoxina A y citrinina, además de penicilina.

En cuanto al género Aspergillus, se aisló en un bajo porcentaje (2%). Varios estudios sugieren que este género se vuelve predominante en productos con un período más prolongado de secado, especialmente cuando la temperatura aumenta y la actividad de agua disminuye31. A. flavus y A. parasiticus producen aflatoxina B1 (AFB1) cuando crecen en productos de larga maduración como el jamón crudo-curado, al igual que A. ochraceus, Penicillium nordicum y P. verrucosum que producen ocratoxina
A, o P. expansum y P. griseofulvum que producen patulina24. Parussolo et al. 32 determinaron una serie de factores que conducen a la contaminación por mohos no deseados durante la producción. En este sentido, el aire del ambiente ha sido descrito como la principal fuente de contaminación, tanto en quesos como en productos cárnicos, durante su elaboración. Estos autores aislaron A. westerdijkiae, tanto en embutidos como en el aire de una planta elaboradora de embutidos crudo-curados secos. Esta especie representa un peligro en cuanto a la producción de OTA, la micotoxina con mayor relevancia en los productos cárnicos.
Por otra parte, si bien Cladosporium es uno de los géneros más frecuentemente hallados en el entorno de procesamiento de productos cárnicos 33;34;35, no representa un riesgo para la inocuidad de estos productos. Ciertas especies provocan cambios indeseables, como manchas negras en la superficie que alteran la calidad sensorial36
Se identificó un 13% de presencia de Alternaria en los secaderos estudiados (Gráfico 1), con mayor predominancia en la empresa B, en donde el secadero tenía infraestructura precaria con suelo de tierra, siendo éste un ambiente favorable para el desarrollo de las especies de este género, las cuales producen al menos 70 metabolitos secundarios de naturaleza tóxica37 A. infectoria, productora de alternariol, fue aislada de una fábrica de productos cárnicos de embutidos secos en la Argentina durante las estaciones climáticas de primavera y verano16
En cuanto al aislamiento de especies del género Fusarium, su hallazgo podría deberse a la utilización de tripas naturales para embutir (empresa B), las cuales podrían contener estructuras fúngicas como contaminantes de este insumo, o haber sido vehiculizadas por las diferentes especias utilizadas en la formulación de la mezcla cárnica. Las especies de este género son capaces de subsistir en los productos almacenados como granos y especias. Si la aw y las condiciones ecológicas son favorables, crecen produciendo alteraciones organolépticas y potentes micotoxinas38.
González et al. 10 demostraron la toxicidad frente a A. salina de tres aislamientos fúngicos provenientes de salames secos, adquiridos en la cadena comercial de la ciudad de Santa Fe, identificados como P. brevicompactum Dierckx (MT), P. chrysogenum Thom (T) y P. commune Thom (T). De igual forma, Galvalisi-Carzoglio 8 realizaron el mismo bioensayo frente a los aislamientos fúngicos obtenidos en una planta elaboradora de embutidos secos. Reportaron que las cepas pertenecientes a las especies P. coprophilum y P. paneum, provenientes de salamines, presentaron una toxicidad leve (DT), mientras que las cepas pertenecientes a las especies P. vanluykii y P. crustosum no fueron tóxicas (NT). Estos autores señalaron, además, que en la especialidad “chacareros” las cepas aisladas pertenecientes a las especies P. glabrum, P. vanluykii, T. amestolkiae y C. cladosporioides fueron no tóxicas (NT), mientras que las pertenecientes a P. paneum y P. nalgiovense fueron débilmente tóxicas (DT).
En las empresas involucradas en el presente estudio, se observaron irregularidades en la implementación de los sistemas de aseguramiento de la calidad (PPR), falta de control de las variables críticas del proceso (pH, aw, temperatura del producto), ausencia de registros y monitoreo microbiológico del producto en proceso. En un estudio39 se demostró que bajo condiciones de temperatura y HRA no controladas, alejadas de las condiciones óptimas que se establecen para la elaboración de embutidos crudo-curados secos, no resultaba suficiente la incorporación de CIF como barrera para la obtención de un producto inocuo y de óptima calidad sensorial. Parussolo et al.32 evaluaron la diversidad de hongos en el aire de las instalaciones, las materias primas y la superficie de embutidos fermentados secos, elaborados en dos industrias ubicadas en el sur de Brasil. Observaron que la variación de los hongos aislados en estas industrias, ubicadas en la misma ciudad, se debía principalmente al aire de las instalaciones el cual juega un rol principal en el mantenimiento de una especie en el entorno de producción. Cotón et al., 6 realizaron una investigación a escala laboratorio y a escala piloto donde utilizaron escenarios de conservación que variaron de 60 a 120 días con todas las muestras almacenadas a temperatura ambiente. Demostraron, en comparación con los embutidos inoculados con CIF, microbiota superficial más diversificada, en especial al momento de la salida del producto del secadero. La microbiota, condicionada por el entorno del proceso y el ambiente de los secaderos, incluía especies micotoxigénicas. Por otra parte, los productos inoculados con CIF y sujetos a controles estrictos de temperatura, HRA y velocidad del aire de secado, con tiempos adecuados de maduración (superior a los 20 días), evidenciaron una mayor prevalencia del hongo usado como starter, mientras que las especies ambientales indeseables se desarrollaban muy poco.
Conclusiones
El relevamiento estacional de la microflora fúngica, realizada en los secaderos de dos empresas chacineras de la ciudad de Santa Fe, demostró que un 48% de los aislamientos pertenecían a especies reportadas como toxicogénicas. De éstas, un 54% resultaron T o DT frente a Artemia salina.
La falta de controles y monitoreo de las variables críticas del proceso, sumado a la ausencia de registros de los PPR, contribuyeron al aspecto y condiciones inadecuadas observadas en ambos establecimientos, independientemente de su proceso productivo (automatizado-artesanal; uso/no uso de CIF).
Debido a que la producción de micotoxinas (y de otros metabolitos secundarios de interés toxicológico) depende más de factores extrínsecos e intrínsecos que del crecimiento del hongo en sí, una adecuada higienización del entorno industrial (incluyendo el aire) asociado a un Plan de Monitoreo Ambiental (PMA), así como el cumplimento de los PPR, resultan cruciales para controlar el desarrollo de especies de hongos indeseables en ambos establecimientos.
El presente trabajo identificó el riesgo químico asociado a la presencia de hongos ambientales toxicogénicos y micotoxicogénicos que crecen sobre el producto durante su maduración y secado. Como el ambiente de los secaderos representa una zona crítica (próxima al producto), la frecuencia de muestreo y el monitoreo continuo de la presencia de estos hongos (asociada al tipo de producto: listo para consumo y su destino: público en general) debería basarse en el riesgo identificado a fin de poder gestionarlo.
Referencias Bibliogr Ficas
(1) Alapont C; López-Mendoza MC; Gil JV & MartínezCulebras PV. (2014). “Mycobiota and toxigenic Penicillium species on two Spanish dry-cured ham manufacturing plants”. Food Additives & Contaminants: Part A, 31(1), 93-104.
(2) Asensio MA; Núñez F; Delgado J & Bermúdez E. (2014). “Control of toxigenic molds in food processing”. Microbial Food Safety and Preservation Techniques; Rai, VR, Bai, AJ, Eds, 329-357.
(3) Castellari C. (2006). “Caracterización de la micobiota superficial de productos cárnicos embutidos secos y selección de cepas fúngicas para la elaboración de cultivos iniciadores (Doctoral dissertation, Tesis de Magister Scientiae. Facultad de Ciencias Agrarias, Universidad Nacional de Mar del Plata. Argentina).
(4) Castellari C; Quadrelli AM &Laich FS. (2008). “Especies fúngicas micotoxigénicas en la superficie de productos cárnicos embutidos secos”. 6º Congreso latinoamericano de Micología. Mar del Plata.
(5) Castellari C; Quadrelli A&Laich F. (2010). “Surface mycobiota on Argentinian dry fermented sausages”. International Journal of Food Microbiology. 142:149-55.
(6) Coton M; Deniel F; Mounier J; JoubrelR;Robieu E;Pawtowski A&Frémaux B. (2021). “Microbial Ecology of French Dry Fermented Sausages and Mycotoxin Risk Evaluation During Storage”. Frontiers in Microbiology. 12, 737140.
(7) Dall’Asta C; Galaverna G; Bertuzzi T; Moseriti A; Pietri A; Dossena A &Marchelli R. (2010). “Occurrence of ochratoxin A in raw ham muscle, salami and dry-cured ham from pigs fed with contaminated diet”.Food Chemistry.120:978-83.
(8) GalvalisiCarzoglio U. (2016). “Hongos filamentosos presentes en productos cárnicos fermentados secos”. Tesis doctoral para optar al título de doctor en biología. Facultad de Ciencias. Facultad de Ingeniería. Disponible en URL:https://www.colibri.udelar.edu.uy/jspui/bitstream/20.500.12008/10159/1/uy24-18300.pdf
(9) Galvalisi U, Lupo S, Piccini J, Bettucci L. (2012) “Penicilliumspeciespresent in Uruguayan salami”. Revista Argentina de Microbiología. 44:36-42
(10) González AM; Presa M; Latorre MG&Lurá MC (2007). “Detection of fungal metabolites showing toxic activity through Artemia salina bioassay”. Revistaiberoamericana de Micologia. 24(1):59-61.
(11) HarwigJ & Scott P. (1971). “Brine shrimp (Artemia salina L.)larvae as a screening system for fungal toxins”. Applied microbiology, 21(6):1011-6.
(12) Iacumin L; Chiesa L; Boscolo D; Manzano M; Cantoni C &Orlic S. (2009). “Moulds and ochratoxin A on surfaces of artisanal and industrial dry sausages”. FoodMicrobiol.26: 65-70.
(13) Juárez BM. (2005). “Estudio de las comunidades microbianas de embutidos fermentados ligeramente acidificados mediante técnicas moleculares.
Estandarización, seguridad y mejora tecnológica”. Tesis Doctoral. Universitat de Girona, Italia.
(14) Laich F; Fierro F& Martín JF. (2002). “Production of Penicillin by Fungi Growing on food products: identification of a complete penicillin gene cluster in Penicillium griseofulvum and a truncated cluster in Penicillium verrucosum”. Applied and Environmental Microbiology.68(3):1211-9.
(15) Latorre Rapela MG;Gonzalez AM&Lurá MC (2005) “Determinación de la actividad antibacteriana de hongos del género Penicillium presentes en embutidos secos”. Revista FABICIB. (9):175-80.
(16) López de Goicoechea, A. (2010). “Especies fúngicas micotoxigénicas en productos cárnicos embutidos secos”.Trabajo de tesis para optar al título de Ing. Técnico agrícola. Universidad Nacional de Mar del Plata y universidad Pública de Navarra. Balcarce, Argentina.
(17) López-Diaz T; Santos J; García-López M& Otero A. (2001). “Surface mycoflora of a Spanish fermented meat sausage and toxigenicity of Penicillium isolates”. International Journal of Food Microbiology. 68:69-74.
(18) Ludemann V.; Pose G; Pollio ML & Segura J. (2004). “Surface mycroflora of Argentine an dry fermented sausages and toxigenicity of Penicillium isolates”. International Journal of Food Technology. (2): 288-92.
(19) Moracanin S; Karan D;Milicévic D&Stjepanovic A. (2008). “The presence of undesiderablemould species on the Surface of dry sausages”. Matice srpskezaprirodnenauke. Número 114.97-103.
(20) Peromingo B; Sulyok M; Lemmens M; Rodríguez A & Rodríguez, M. (2019). Diffusion of mycotoxins and secondary metabolites in dry-cured meat products.Food Control. 101:144-50.
(21) Pitt J& Hocking A. (1999). “Fungi and food spoilage”. 2° Ed. Aspen Publisher Inc. Gaithersburg, Maryland.
(22) Pose, G.; Ludemann, V.; Pollio, M.L.; Segura, J. (2004). Microflora autóctona de la superficie de embutidos secos fermentados. Mundo lácteo y cárnico 4:12-14.
(23) Rivas G; Sánchez M; Vladés La Hens D; Semorile L y Delfederico L. (2019) “Bacterias indígenas en embutidos secos fermentados: capacidad de implantación e implicancias en la calidad del producto”. Comunicación a Congreso. XV CAM. Buenos Aires, Argentina.
(24) Rodríguez A; Rodríguez M; Martín A; Delgado J & Córdoba JJ. (2012a). “Presence of ochratoxin A on the surface of dry-cured Iberian ham after initial fungal growth in the drying stage”. Meat Science. 92:728-34.
(25) Rodríguez A; Rodríguez M; Martín A; NúñezF& Córdoba JJ. (2012b). “Evaluation of hazard of aflatoxin B1, ochratoxin A and patulin production in dry-cured ham and early detection of producing moulds by qPCR”. Food Control. 27:118-26.
(26) Scheuer R. (1995). “UntersuchungenzurBildung von Verrucosidin auf Rohwurst”. Mitteilungsblatt der Bundesanstalt für Fleischforschung, Kulmbach. 34:199205.
(27) Sonjack S;Licen M;Frisvand J; Gunde-Cimerman N. (2010). “The mycobiota of three dry-cured meat products from Slovenia”. FoodMicrobiology. Vol 30. 1-4.
(28) Tevez Ciappino M; Oberlander, M; Bravo, R; Paz, M y Nediani, M. (2019). “Actividad antimicrobiana de Penicillium aislados de superficie de salamines artesanales a base de carne caprina de Santiago del Estero”. Comunicación a Congreso. XV CAM. Buenos Aires, Argentina.
(29) Vila, G. (2015). “Caracterización morfológica, bioquímica y molecular de la población fúngica de embutidos secos fermentados de las principales localidades productoras de la República Argentina”.Tesis de maestría. Universidad Nacional de Río Negro y Universidad Nacional de Quilmes. Argentina.
(30) Canel, RS; WagnerJR;Stenglein SA &Ludemann V. (2013). ”Indigenous filamentous fungi on the surface of Argentinean dry fermented sausages produced in Colonia Caroya (Córdoba)”. International Journal of Food Microbiology, 164(1):81-6.
(31) Magistà D; SuscaA; Ferrara M;Logrieco AF& Perrone G. (2017). “Penicillium species: Crossroad between quality and safety of cured meat production”. Current Opinion in Food Science. 17:36-40
(32) Parussolo G; Oliveira MS;Garcia MV;Bernardi AO; Lemos JG;Stefanello A&CopettiMV. (2019). “Ochratoxin A production by Aspergillus westerdijkiae in Italian-type salami”. Food Microb. 83:134-40.
(33) Andersen SJ. (1995). “Compositional changes in surface mycoflora during ripening of naturally fermented sausages”. Journal of Food Protection. 58(4):426-9.
(34) Mižáková A; Pipová M&Turek P. (2002). “The occurrence of moulds in fermented raw meat products”. Czech J Food Sci- 20(3):89-94.
(35) Sørensen LM; Jacobsen T; Nielsen PV; Frisvad JC& Koch AG. (2008). “Mycobiota in the processing areas of two different meat products”. International Journal of Food Microbiology. 124(1):58-64.
(36) Alía A; Andrade MJ; Rodríguez A; Reyes-Prieto M; Bernáldez V & Córdoba JJ. (2016). “Identification and control of moulds responsible for black spot spoilage in dry-cured ham”. Meat Science. 122:16-24.
(37) Terminiello L; Patriarca A; Pose G & Fernández Pinto V. (2006). “Occurrence of alternariol, alternariol monomethyl ether and tenuazonic acid in Argentinean tomato puree”. Mycotoxin Research. 22(4):236-40.
(38) Piontelli Laforet (2013). “Morfología delos hongos comunes en ambientes internos y externos”.Cap. 6, págs:149-439.
(39) Cervellini A;NarioF & Díaz M. (2015). “Mejora de la seguridad alimentaria en embutidos secos mediante el uso de starters”. Tesina de la Orientación Tecnológica de los Alimentos. Universidad Nacional del Centro de la Provincia de Buenos Aires (UNCPBA, Tandil, Argentina).
ANIVERSARIO
1966 - 2023